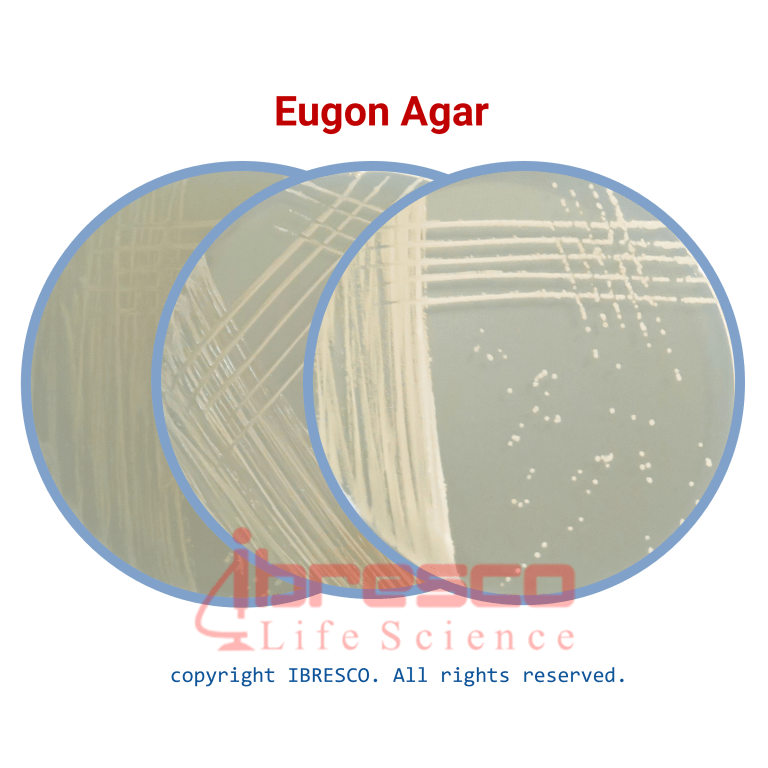
Eugen-768x768

Eugon Agar | اگون آگار ایبرسکو
Eugon Agar | اگون آگار ایبرسکو
دانلود سرتیفیکیت Eugon Agar | اگون آگار ایبرسکو
کاربرد: محیط کشت توصیه شده برای طیف وسیعی از میکروارگانیسم ها از جمله میکروارگانسم های سخت رشد مانند سویه های Heamophilus، Neisseria، Pasteurella، Brucella و Lactobacillus
دسته: محیط کشت
ویژگی ها
- ضمانت اصالت کالا
- ارسال سریع کالا
- مشاوره کاهش هزینه ها
- خرید بهترین برندهای خارجی و داخلی با قیمت مناسب
- پشتیبانی 24 ساعته
- امکان سفارش در حجم و اندازه مورد نیاز بسیاری از محصولات
- 8161 351 935 98+
Eugon Agar | اگون آگار ایبرسکو
کاربرد: محیط کشت توصیه شده برای طیف وسیعی از میکروارگانیسم ها از جمله میکروارگانسم های سخت رشد مانند سویه های Heamophilus، Neisseria، Pasteurella، Brucella و Lactobacillus
آماده سازی محیط
- قوطی حاوی پودر محیط کشت اگون آگار را به خوبی تکان دهید. مقدار 44.4 گرم از پودر را وزن کنید و در 1 لیتر آب مقطر حل کنید.
- به آرامی حرارت دهید تا محیط کاملا حل شود.
- به مدت 15 دقیقه در دمای 121 درجه سانتی گراد اتوکلاو کنید.
- اجازده دهید تا دمای 50-45 درجه سانتی گراد خنک شود.
- در صورت نیاز 10-5% حجمی/حجمی خون دفیبرینه اضافه کنید. اگر پلیت های شکلات آگار نیاز است، پس از افزودن خون نیز حرارت دهید.
- در پتری دیش های استریل بریزید.
نکته
- برای شناسایی کامل باکتری های، به تست های بیوشیمیایی نیاز است.
شرایط نگهداری
پودر محیط داخل قوطی کاملا در بسته و در دمای زیر 30 درجه سانتیگراد و محیط آماده در دمای 8-2 درجه سانتیگراد نگهداری شود. بهترین زمان استفاده تا قبل از تاریخ انقضای درج شده بر روی برچسب محصول است.
کنترل کیفی
- ظاهر محیط دهیدراته: پودر یکنواخت، بژ
- ظاهر محیط آماده: کهربایی روشن، کمی کدر، ممکن است رسوب سیستئین مشاهده شود.
- نتیجه کشت باکتری پس از گرماگذاری در دمای 2 ± 35 درجه سانتی گراد به مدت 48-18 ساعت.
- برای کشت Candida albicans و Aspergillus brasiliens از محیط براث تازه، تلقیح را انجام دهید و به مدت 48-18 ساعت در دمای 2 ± 30 درجه سانتی گراد گرماگذاری کنید.
| Recovery | ATCC | Organism |
|---|---|---|
|
Good
|
26790
|
Candida albicans
|
|
Good
|
19615
|
Streptococcus pyogenes
|
|
Good
|
12022
|
Shigella flexneri
|
|
Fair to good
|
16404
|
Aspergillus brasiliensis (niger)
|
| گرم بر لیتر | ترکیبات |
|---|---|
|
15
|
Tryptone
|
|
5
|
Soya peptone
|
|
5
|
Dextrose (Glucose)
|
|
4
|
Sodium chloride
|
|
0.2
|
Sodium sulphite
|
|
0.2
|
L-Cystine
|
|
15
|
Agar
|
|
0.2 ± 7
|
pH
|
نمره 0 از 5
0 دیدگاه
نمره 5 از 5
0
نمره 4 از 5
0
نمره 3 از 5
0
نمره 2 از 5
0
نمره 1 از 5
0
اولین نفری باشید که دیدگاهی را ارسال می کنید برای “Eugon Agar | اگون آگار ایبرسکو” لغو پاسخ
محصولات پیشنهادی
دیدگاهها
حذف فیلترهاهیچ دیدگاهی برای این محصول نوشته نشده است.